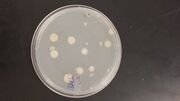
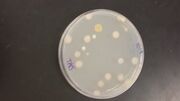
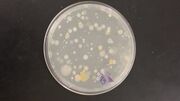

Uploads by Aijah Raghnal
From OpenWetWare
Jump to navigationJump to search
This special page shows all uploaded files.
| Date | Name | Thumbnail | Size | Description |
|---|---|---|---|---|
| 03:34, 1 March 2016 | Rsz 1rsz 20160229 222657.jpg (file) |  |
53 KB | |
| 03:33, 1 March 2016 | Rsz 1rsz 20160229 222652.jpg (file) |  |
72 KB | |
| 03:23, 1 March 2016 | Rsz 2rsz 1rsz 20160227 180559.jpg (file) |  |
80 KB | |
| 02:46, 26 February 2016 | Rsz 1rsz 1rsz 1rsz 20160225 213050.jpg (file) |  |
77 KB | |
| 02:45, 26 February 2016 | Rsz 1rsz 1rsz 20160225 213039.jpg (file) |  |
70 KB | |
| 05:50, 25 February 2016 | Rsz 1rsz 1rsz 20160225 004142.jpg (file) |  |
31 KB | |
| 02:18, 25 February 2016 | Rsz 1rsz food web.jpg (file) |  |
16 KB | |
| 18:59, 21 February 2016 | Rsz 1rsz 120160221 134629.jpg (file) |  |
28 KB | |
| 18:20, 21 February 2016 | Rsz 30523 580 360.jpg (file) |  |
9 KB | Image courtesy of Encyclopedia of Life |
| 21:10, 20 February 2016 | Rsz 1rsz 11744 580 360.jpg (file) |  |
10 KB | Image courtesy of Encyclopedia of Life |
| 19:54, 18 February 2016 | Rsz 12058 580 360.jpg (file) |  |
8 KB | |
| 19:37, 18 February 2016 | Rsz 1rsz american woodcock.jpg (file) |  |
19 KB | Image courtesy of Encylopedia of life: http://eol.org/pages/1049378/overview |
| 19:35, 18 February 2016 | Rsz 1rsz killdeer.jpg (file) |  |
23 KB | Image courtesy of Encyclopedia of Life. http://eol.org/pages/1049356/overview |
| 19:08, 18 February 2016 | Rsz 1rsz 20160218 134431.jpg (file) |  |
34 KB | |
| 07:43, 11 February 2016 | Rsz 1rsz 1rsz 20160211 023301.jpg (file) |  |
24 KB | |
| 07:43, 11 February 2016 | Rsz 2rsz 20160205 101003.jpg (file) |  |
6 KB | |
| 07:43, 11 February 2016 | Rsz 1rsz 20160205 100831.jpg (file) |  |
16 KB | |
| 07:42, 11 February 2016 | Rsz 1rsz 20160205 100726.jpg (file) |  |
12 KB | |
| 07:42, 11 February 2016 | Rsz 1rsz 20160205 100551.jpg (file) |  |
13 KB | |
| 07:42, 11 February 2016 | Rsz 1rsz 1rsz 20160205 100147.jpg (file) |  |
19 KB | |
| 18:48, 7 February 2016 | Rsz 1rsz img 0295.jpg (file) |  |
4 KB | |
| 18:47, 7 February 2016 | Rsz 1rsz 1rsz img 0291.jpg (file) |  |
4 KB | |
| 18:47, 7 February 2016 | Rsz 1rsz 1img 0294.jpg (file) |  |
7 KB | |
| 18:45, 7 February 2016 | Rsz 1rsz 1img 0292.jpg (file) |  |
5 KB | |
| 18:42, 7 February 2016 | Rsz 1rsz 20160129 094236.jpg (file) |  |
16 KB | |
| 18:41, 7 February 2016 | Rsz 1rsz 20160129 094225.jpg (file) |  |
19 KB | |
| 18:40, 7 February 2016 | Rsz 1rsz 20160129 094217.jpg (file) |  |
16 KB | |
| 18:40, 7 February 2016 | Rsz 1rsz 20160129 094202.jpg (file) |  |
19 KB | |
| 18:36, 7 February 2016 | Rsz 1rsz 120160129 094255.jpg (file) | |
16 KB | 10^-9 |
| 18:35, 7 February 2016 | Rsz 1rsz 20160129 094314.jpg (file) | |
15 KB | |
| 18:35, 7 February 2016 | Rsz 1rsz 20160129 094308.jpg (file) |  |
18 KB | 10^-5 |
| 18:34, 7 February 2016 | Rsz 1rsz 20160129 094247.jpg (file) | |
18 KB | 10^-3 |
| 18:32, 7 February 2016 | Rsz 1rsz 20160205 013958.jpg (file) |  |
43 KB | |
| 06:29, 29 January 2016 | Rsz 1rsz 20160129 012501.jpg (file) |  |
74 KB | |
| 19:53, 28 January 2016 | Rsz 11rsz 20160128 142603.jpg (file) |  |
27 KB | |
| 19:50, 28 January 2016 | Rsz 1rsz 2rsz 20160128 142603.jpg (file) |  |
16 KB | |
| 19:50, 28 January 2016 | Rsz 1rsz 1rsz 20160122 101314.jpg (file) |  |
18 KB | |
| 19:49, 28 January 2016 | Rsz 1rsz 1rsz 2rsz 20160122 101328.jpg (file) |  |
17 KB | |
| 20:15, 18 January 2016 | 20160115 093045.jpg (file) |  |
53 KB | |
| 20:14, 18 January 2016 | 20160115 092637.jpg (file) |  |
60 KB | |
| 20:12, 18 January 2016 | 20160115 093035.jpg (file) |  |
58 KB | |
| 20:08, 18 January 2016 | 20160115 092903.jpg (file) |  |
53 KB | |
| 20:04, 18 January 2016 | 20160115 092655.jpg (file) |  |
101 KB | |
| 16:43, 16 January 2016 | Rsz 1rsz 1rsz 20160115 092644.jpg (file) |  |
158 KB | |
| 16:35, 16 January 2016 | 20160115 092644.jpg (file) |  |
9.01 MB |